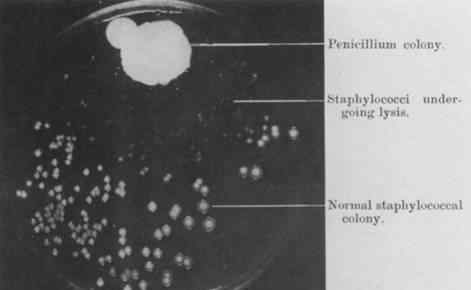

第一次世界大战期间,皇家陆军医疗队队长亚历山大·弗莱明在法国呆了一段时间。他发现法国佛兰德斯战场上的伤口污秽不堪,泥浆随着武器高速运转切入士兵体内,会使伤口的后果更加严重。当时没有抗生素,伤口只能用消毒剂处理。但是,用大量的消毒剂冲洗伤口的副作用是不可忽视的——消毒剂杀死了伤口中的细菌,也杀死了人体的正常细胞。
人们希望找到一种能特异性杀死细菌的药物,但这是人类未知的领域,谁也不知道谁会有幸打开新世界之门。第一次世界大战结束后,弗莱明回到伦敦工作,开始专心研究感染伤口中最常见的细菌葡萄球菌,并试图找出如何杀死它们。
1928年9月,弗莱明度假归来。放假前,他把所有的细菌培养基都堆在实验室角落的长椅上。结果他发现其中一个培养基意外被霉菌污染,霉菌周围的葡萄球菌全部被杀死。当时卫生条件不好。培养基被污染是很常见的。大多数研究人员会扔掉不正常的培养基。只有弗莱明做了一个著名的评论:“这个很有意思。”
弗莱明污染介质
弗莱明认为,霉菌会分泌一些可以杀死葡萄球菌的物质。于是他趁热打铁,小心翼翼地从培养基中提取霉菌,提纯培养,发现这些霉菌其实是青霉菌,它们的分泌物可以杀死一些引起人类疾病的葡萄球菌。
霉菌杀死细菌的情况并不少见,半个世纪前约翰·廷德尔就有过这样的描述。1876年,廷德尔在观察一块羊肉的腐烂过程时,注意到上面生长的细菌可以被霉菌杀死。Tindal记录了这种霉菌的名字,青霉素,并这样记录道:“霉菌厚而连贯的地方,细菌死亡,或者进入休眠状态。”19世纪的其他科学家,包括巴斯德、李斯特等人,也曾尝试用青霉菌治疗感染伤口,但由于手术难度大,最终放弃了。
弗莱明决定从这里开始,找出青霉菌杀死葡萄球菌的秘密。他试图提纯这种杀菌物质,但失败了:成品中含有太多杂质,弗莱明非常清楚这种混合物绝不能不小心注射到人体内。屡遭失败的弗莱明终于放弃了青霉素的治疗价值。1929年,他发表了一篇题为《青霉菌的抗菌行为——特别提及它们在分离乙型流感病毒中的应用》的医学论文,作为他对青霉菌研究的结束。在这篇文章中,他彻底放弃了用青霉素作为药物的想法,主要讲了用青霉菌分离乙型流感病毒的方法:因为青霉素可以杀死很多细菌,但不能伤害乙型流感病毒,只要将青霉菌滴入培养皿中,就可以获得纯化的乙型流感病毒,这对研究乙型流感病毒的微生物学家来说是个好消息。
放弃青霉素的弗莱明转向了别的东西。但是,出于微弱的希望,他还是在培养皿中培养青霉菌,偶尔谈起青霉素,坚信它可能是人类的宝贵财富。
一个叫塞西尔·乔治·潘恩的医生,学生时代曾经在弗莱明的报告里了解到青霉菌,他对它很感兴趣。所以他参加工作的时候给弗莱明写信,要了一些青霉菌的样本。潘恩把青霉菌汁液的提取物给了三个皮肤感染的病人,但是没有好转。帕恩并不沮丧。根据现有的医疗记录,他后来将含有青霉菌的培养液滴入一名眼睛感染淋球菌的三个月大婴儿的眼睛。1930年11月25日,医学文件上写着“开始使用青霉素”。过了几天,12月2日,宝宝的眼睛完全干净了,那些化脓都消失了。潘恩回忆道:“青霉素像咒语一样起作用。”后来,潘恩用类似的方法治愈了一个眼睛被石头碎片刺穿,眼球感染肺炎球菌的矿工。矿工痊愈出院,视力恢复。
可悲的是,1931年3月底,潘恩去伦敦研究产后发热,此后他再也没有用过青霉素。他可能是世界上第一个在临床实践中发现青霉素治疗价值的人,但他错过了改变历史的机会。晚年有人采访他,问他在青霉素的发现和应用中的作用时,他回答说:“没什么。一个可怜的傻瓜,青霉素在他面前的时候我没看见。我觉得有很多事情阻碍了我学习青霉素。我很难过,但这是事实。如果我有点运气,它可能会更早来到这个世界。”潘恩的遗憾不仅在于他失去了名誉和财富,还在于如果他能完成许多伟人如巴斯德未能完成的事业,许多人的死亡和疾病就可以避免。
青霉菌就这么尘封了将近十年,然后是20世纪40年代。
1940年,来自英国牛津的两位科学家弗洛里和恩斯特·鲍里斯·钱恩在小鼠身上测试了青霉素的功效,并成功提取了一些青霉素。这项研究绝非易事。甚至可以说是一次危及生命的冒险。在二战最惨淡的日子里,弗洛里和恩斯特·鲍里斯·钱恩不得不面对英国可能被打败的现实。他们一度想摧毁实验室,烧毁所有实验记录,以防止青霉素这种厉害的东西落入希特勒的德意志帝国手中。他们计划把青霉素藏在体内,一旦德国入侵,他们就四处逃亡。他们希望至少有一个人能在混乱的战争中幸存下来,到达远离大洋彼岸战场的美国,在那里继续他们的研究。

弗洛里

恩斯特·鲍里斯·金
幸好德国没有去英国。1941年,弗洛里和恩斯特·鲍里斯·钱恩为阿尔伯特·亚历山大治疗了一名面部严重感染的警察。疗效很好,警察病情好转很快。可惜他们提取的盘尼西林不够,药也用光了,警察终于死了。
这个案例让人们发现了青霉素的威力。此外,随着二战的爆发,大量伤员急需救治,青霉素的生产工艺迅速发展。1943年,青霉素成为美国第二重要的高端研究项目,开始实现工业化生产。到1945年6月,青霉素年产量已达6469亿单位,美国每个月生产的青霉素可以治愈4万人。青霉素挽救了成千上万伤病员的生命,开创了百花齐放的抗生素时代。因此,1945年诺贝尔生理医学奖授予了弗莱明、弗洛里和钱恩。

青霉素化学结构式
1.《青霉素发明于 鲜为人知的青霉素发明背后离奇的故事》援引自互联网,旨在传递更多网络信息知识,仅代表作者本人观点,与本网站无关,侵删请联系页脚下方联系方式。
2.《青霉素发明于 鲜为人知的青霉素发明背后离奇的故事》仅供读者参考,本网站未对该内容进行证实,对其原创性、真实性、完整性、及时性不作任何保证。
3.文章转载时请保留本站内容来源地址,https://www.lu-xu.com/yule/1802459.html